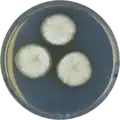
Aspergillus egyptiacus growing on CYA plate

Aspergillus egyptiacus
| Aspergillus egyptiacus | |
|---|---|
| Scientific classification | |
| Kingdom: | Fungi |
| Division: | Ascomycota |
| Class: | Eurotiomycetes |
| Order: | Eurotiales |
| Family: | Aspergillaceae |
| Genus: | Aspergillus |
| Species: | A. egyptiacus
|
| Binomial name | |
| Aspergillus egyptiacus Moubasher & Moustafa (1972)[1]
| |
Aspergillus egyptiacus is a species of fungus in the genus Aspergillus. It is from the Cavernicolus section.[2] The species was first described in 1972.[1] It was isolated from sandy soil in Egypt.[2]
Growth and morphology
A. egyptiacus has been cultivated on both Czapek yeast extract agar (CYA) plates and Malt Extract Agar Oxoid® (MEAOX) plates. The growth morphology of the colonies can be seen in the pictures below.
-
Aspergillus egyptiacus growing on CYA plate
Aspergillus egyptiacus growing on CYA plate -
 Aspergillus egyptiacus growing on MEAOX plate
Aspergillus egyptiacus growing on MEAOX plate
References
- ^ a b Moubasher & Moustafa 1972, Egypt. J. Bot. 15: 153
- ^ a b Chen, A.J.; Frisvad, J.C.; Sun, B.D.; Varga, S.; Kocsubé, S.; Dijksterhuis, J.; Kim, D.H.; Hong, S.-B.; Houbraken, J.; Samson, R.A. (2016). "Aspergillus section Nidulantes (formerly Emericella): Polyphasic taxonomy, chemistry and biology". Studies in Mycology. 84: 1–118. doi:10.1016/j.simyco.2016.10.001. PMC 5198626. PMID 28050053.
Further reading
- Richard J., Cole (2012). Modern Methods in the Analysis and Structural Elucidation of Mycotoxins. Oxford: Elsevier Science. ISBN 978-0-323-14853-5.
- Zhu, editors, Jian Chen, Yang (2014). Solid state fermentation for foods and beverages. Boca Raton: CRC Press, Taylor & Francis Group. ISBN 978-1-439-84496-0.
{{cite book}}:|first1=has generic name (help)CS1 maint: multiple names: authors list (link) - Zohri, AA; Ismail, MA (1994). "Based on biochemical and physiological behavior, where is Aspergillus egyptiacus better placed?". Folia Microbiologica. 39 (5): 415–9. doi:10.1007/BF02814449. PMID 7537240. S2CID 33580083.
- Ismail, M.A.; Zohri, A.A. (March 1994). "Confirmation of the relationships of Aspergillus egyptiacus and Emericella nidulans using progesterone transformation". Letters in Applied Microbiology. 18 (3): 130–131. doi:10.1111/j.1472-765X.1994.tb00825.x. S2CID 84983290.